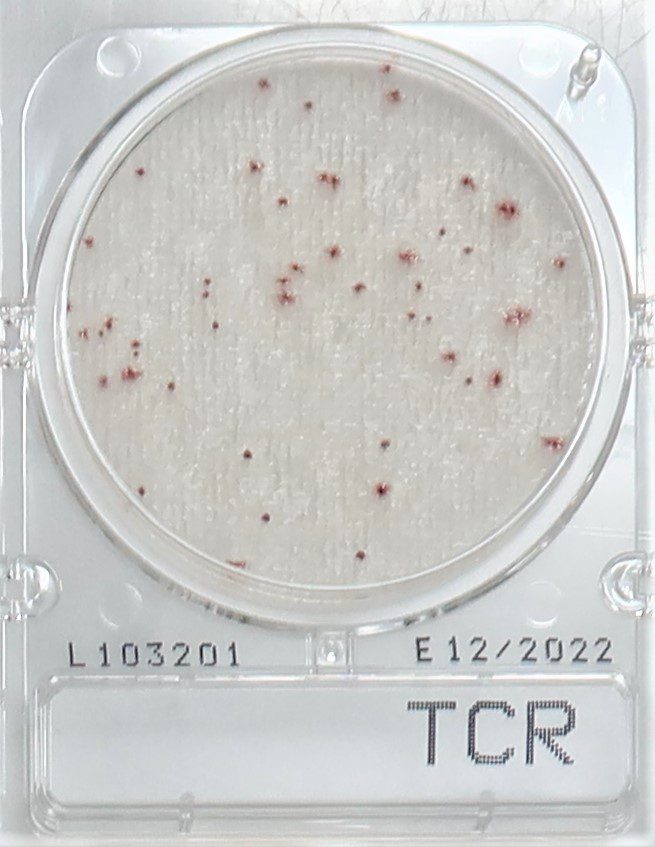

This non-specific test detects a broad range of pathogens but without direct identification.
Total Viable Count (TVC) refers to all aerobic microorganisms present in a sample and does not have specific growth requirements.
The Food and Drug Administration’s (FDA) regulation considers Total Count as one of the release parameters for food (frozen, chilled, precooked, and prepared food), pharmaceutical, and nutraceutical samples. A Total Count test is required to verify that a food or beverage sample is free of microbial pathogens to guarantee food safety.